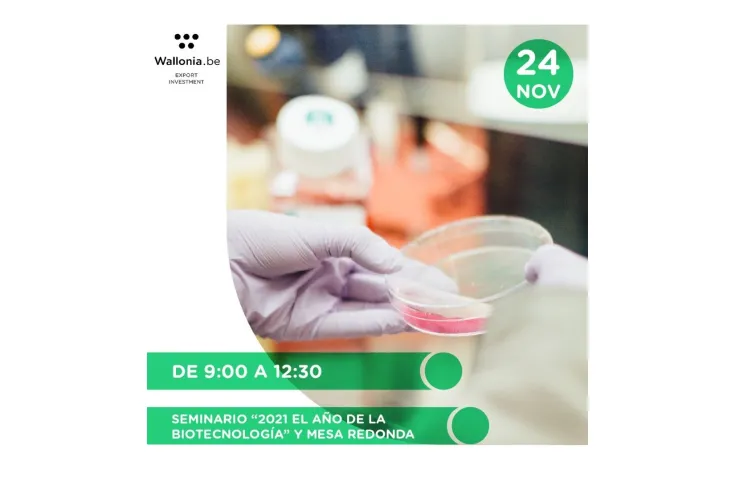
awex wallonia

Buscar
Sumario de resultados
TIpos de contenido
Fecha
-
 Noticia
Noticia#NuevoSocio | "AseBio es un compañero estratégico clave para nuestra empresa"
Conoce a Integra Therapeutics. Hablamos con Avencia Sánchez-Mejías, la directora general de la compañía.
-
 Oferta de empleo
Oferta de empleoSales Manager
-
 Oferta de empleo
Oferta de empleoOferta de Empleo: Full Stack Developer
-
 Noticia
NoticiaORYZON anuncia la inclusión del primer paciente en el estudio EVOLUTION, un ensayo clínic...
Evaluará de forma independiente el efecto de vafidemstat para tratar los síntomas negativos y cognitivos en esquizofrenia Ensayo de Fase IIb adaptativo que prevé reclutar 100 pacientes Segundo ensayo
-
 Noticia
NoticiaAsamblea General AseBio Diciembre 2021 - Elecciones a la Junta Directiva
El próximo 14 de diciembre de 2021 se celebrará la Asamblea General Ordinaria y Extraordinaria de AseBio, a las 11:15h en primera convocatoria y a las 11:30 h en segunda convocatoria. A partir de las
-
-
 Oferta de empleo
Oferta de empleoTécnico de Laboratorio
-
 Noticia
NoticiaPropuesta de Orden por la que se aprueban las bases reguladoras para la concesión de ayuda...
El Ministerio para la Transición Ecológica y el Reto Demográfico ha abierto el trámite de audiencia e información pública sobre la Propuesta de Orden por la que se aprueban las bases reguladoras para
-
 Oferta de empleo
Oferta de empleoLicenciado o grado con máster
-
 Noticia
NoticiaLa biotecnología en el PERTE para la "Salud de Vanguardia"
Rocío Arroyo, CEO de Amadix y coordinadora del Grupo de Trabajo de Medicina Personalizada de AseBio, ha destacado el papel de las empresas biotecnológicas en todo el ciclo de la I+D
-
 Noticia
NoticiaLa biotecnológica NIMGenetics planta un árbol por cada test prenatal TrisoNIM® NeoSeq vend...
La multinacional biotecnológica NIMGenetics, en colaboración con la Asociación (R)Forest Project, ha llevado a cabo una iniciativa de reforestación en la Casa de Campo de Madrid
-
 Noticia
NoticiaTercera convocatoria del Programa REBECA de mentorazgo a jóvenes investigadores
El programa tendrá una duración de seis meses y durante este tiempo, parejas de mentores/as e investigadores/as celebraran reuniones virtuales para reflexionar sobre sus competencias, habilidades y
-
 Noticia
NoticiaORYZON publica un artículo científico en la revista ACS Pharmacology & Translational Scie...
Iadademstat es consistentemente más potente en la reducción de la viabilidad de las células de leucemia mieloide aguda(LMA) y cáncer de pulmón de célula pequeña (CPCP) Mayor capacidad de unión a la
-
 Noticia
NoticiaBúsqueda de socio para proyectos de cooperación con China en el área de Biotecnología Salu...
Proyectos de Cooperación Tecnológica Internacional entre España y China bajo el marco del programa bilateral CHINEKA.
-
-
-
 Nota de prensa
Nota de prensaBiocombustibles, bioplásticos y cultivos resistentes a condiciones extremas, entre las sol...
La COP26 afronta este jueves su penúltima jornada y la asociación recuerda que la biotecnología permite reducir las emisiones de gases de efecto invernadero hasta un 65% El sector tiene un impacto
-
 Oferta de empleo
Oferta de empleoTitulado Medio
-
 Noticia
NoticiaBiocombustibles, bioplásticos y cultivos resistentes a condiciones extremas, entre las sol...
La COP26 afronta este jueves su penúltima jornada y la asociación recuerda que la biotecnología permite reducir las emisiones de gases de efecto invernadero hasta un 65% y que tiene un impacto directo
-
 Noticia
NoticiaAlgenex reconocida como mejor compañía europea en los Animal Health Awards 2021
Su tecnología permite un escalado casi ilimitado a costes muy competitivos. La tecnología CrisBio® está avalada por diferentes agencias reguladoras lo que garantiza la seguridad en la fabricación de
-
 Oferta de empleo
Oferta de empleoPredoctoral